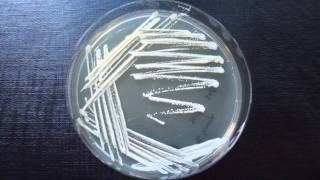
Streak Plate Method - Amrita University
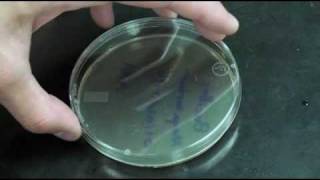
Plate Streaking - WPI | Worcester Polytechnic Institute
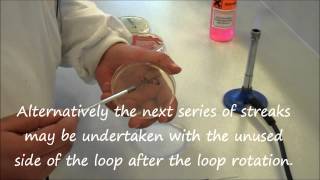
Microbiology: How to streak an agar plate

Song info
"Streaked"
(2017)
on the album III(1997).
0 người yêu thích
"Streaked" Videos
Lyrics
Oh! We don't have the lyrics to this song yet.
- 0 Bản dịch

Recent comments